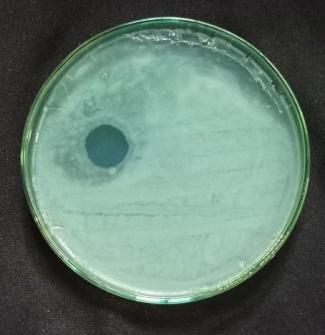
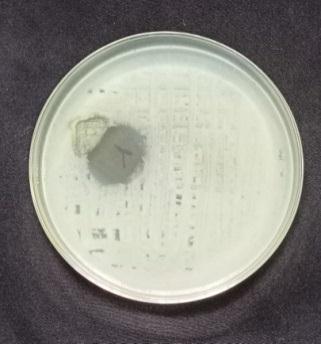
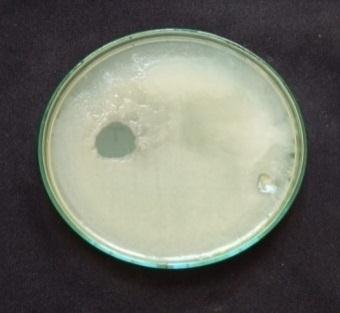

International Research Journal of Engineering and Technology (IRJET) e ISSN:2395 0056

Volume: 09 Issue: 06 | June 2022 www.irjet.net p ISSN:2395 0072

International Research Journal of Engineering and Technology (IRJET) e ISSN:2395 0056

Volume: 09 Issue: 06 | June 2022 www.irjet.net p ISSN:2395 0072
***
ABSTRACT:
In the present study, a composite wound dressing material containing fibrin (F) and regenerated cellulose (RC) impregnated with silver nanoparticles (AgNPs) was developed. The AgNPs was prepared by green synthesis process from AgNO3 solution through the extract from the leaves of plant Atlanta monophyla which have been used in traditional medicine such as Ayurvedic system in India. The average particle size was found to be 50 nm for silver nanoparticles. From the UV Spectroscopy, the formation of stable nanoparticles was confirmed between the 300nm to 700 nm The size of AgNPS and different elements in sample composition was confirmed by TEM and EDX respectively. Antibacterial activity of synthesized silver nanoparticles was carried out in liquid growth medium against four pathogens (Staphylococcus aureus, Bacillus subtilis, Pseudomonas aeruginosa, Escherichia coli) was conducted The bio composites were prepared by using conventional techniques and its invitro cytotoxicity was evaluated by MTT. We found that the RC F Ag bio composite prepared from plant Atalantia monophylla was consider may be a potential candidate as a wound dressing material and may be tried on the clinical woundsofanimalsbeforebeingappliedonhumans.
Key words: Regenerated cellulose, Silver nanoparticles, Atlantia monophyla, wound healing, anti bacterial,
Nanotechnology is one of the most exciting discoveries in contemporary materials engineering. Based on particular properties such as size, disruption, and morphology, nanomaterialsnewandimprovedproperties.Becauseoftheir unique antimicrobial properties, metallic nanoparticles have recently piqued the interest of researchers for use in wound healing as nanotechnology advances. Because of their remarkable properties, Ag NPs have piqued the interest of researchersinrecentdecades.Theyhavealargesurfacearea,
making them a strong contender for antimicrobial effect due to increased contact with micro organisms and potential noxiousness [1]. A high efficiency wound closure material that creates an optimal environment for epidermal regenerationwhilealsoprovidingabarrieragainstwaterloss and infection of the chronic wound is required for proper wound treatment. Infomercial dressings are commonly used forwoundrepair,butthesecomponentsarecertainlydryand can attach to the wound's exterior, causing physical disquiet when excluded. Instead of traditional dressings, new natural wound care products made from bio companionable polymeric sources (such as collagen, elastin, chitosan, and alginates and hyaluronic acid) are now used [2]. These polymeric compounds have the capability to issue bioenergetic ingredients and aid in the rehabilitation progression Traditional wound bandages are incapable of meeting wound care requirements. Because of their unique properties, electro spun nano fiber mats, hydrogels, and nanocomposites, as the new generation of wound dressing, hasten curative and avert pathogenic bacteria. Nanofibrous synthesis with morphometric and architectural possessions comparable to the natural extracellular medium has also been empowered by modern improvements in nanoscience. Nano fibers, hydro gels, and nano composites have high permeability, a large superficial area to volume ratio, and excellent gas permeation. The properties mentioned above improve cell respiration, skin and moisture regeneration, hemostasis, and purulent removal Similarly, many nosocomial pathogens are drug resistant, posing a high risk to patients afflicted with them. As more bacterial strains becomeresistanttoantibiotics,newstrategiesforcombating these pathogens are being developed. The primary wound curative strategy is to combine different non traditional antibacterial agents (such as nanoparticles) to overcome microorganism resistance and gain complementary antimicrobialeffect[3] Acompositewounddressingmaterial containing fibrin (F) and regenerated cellulose (RC) impregnated with silver nanoparticles (AgNPs) was developed in this study. Green synthesis was used to create
International Research Journal of Engineering and Technology (IRJET) e ISSN:2395 0056

Volume: 09 Issue: 06 | June 2022 www.irjet.net p ISSN:2395 0072
Ag NPsfromAgNO3solutionusingextractsfromtheleavesof three different plants, Chloroxylon swietnia, Atlanta monophyla,and Tarennaasiatica,allofwhichhavebeenused intraditionalmedicinesuchastheAyurvedicsysteminIndia. We discovered thattheRC F Agbiomatrix plannedfromthe plant Atalantia monophylla is a potential candidate as a woundmanagementmaterialandshouldbetestedonclinical injuriesinanimalsbeforebeingusedonhumans[4].
Untainted and systematic rating chemicals were used in experiment together with fusion of silver nanoparticles, media groundwork for progress of bacterial cells. silver nitrate (AgNo3) were obtained. The bacterial cultures of Escherichia coli, Staphylococcus aureus, Bacillus subtilis, Pseudomonas aeruginosawere obtained and antibiotics (Gentamicin). Peptone, Sodium chloride, Yeast extract, Beef extract, Agar agar. Vero (African green monkey kidney normal cell line) was obtained from the national center for cellsciences(NCCS),Pune,India.Cellweremaintainedinthe logarithmic phase of growth in Dulbecco’s modified eagle medium (DMEM) supplemented with 10% (v/v) heat inactivated fetal bovine serum (FBS),100µg/ml streptomycin [5].
Weighing 2 g of plant (Atalantiamonophylla) was meticulously eroded in distilled water, dehydrated, cut into fine pieces and smashed into 50 ml distilled water and filtered through Whatmann No.1 filter paper and further filtered.Theextractwasstoredat4°Cforfurtherexperiments [6]
The aqueous solution of 1 mM silver nitrate (AgNo3) was prepared and used for silver control and test. 10 ml of Atalantiamonophylla extractwasaddedinto90mlofaqueous solution of 1mM silver nitrate incubation at RT for 15 hours Ag NPformation.
Ag nanoparticles were characterized in a Perkin Elmer UV VIS Spectrophotometer, Lambda 19 to know the kinetic
behavior of Ag nanoparticles. The Scanning range for the sampleswas300 700nmatascanspeedof480nm/min[7]
TEM analysis was done to visualize the shape and size of synthesized Ag NPs. The sample was dispersed in double distilledwater.Adropofdispersionwasplacedona"staining mat". Carbon coated copper grid was inserted into the drop withthecoatedsiteupwardsafterabout10minutes,thegrid wasremovedandairdried,thenscreenedin JEOL,JEM 2100 transmissionelectronmicroscope.
EDX analysis was conducted in above instrument attached with thermo EDX to confirm the presence of different elementalcompositionofthesample.ThesynthesizedAg NPs wereisolatedbycentrifugationfor20minat10,000rpm.The pelletswerecollectedand driedintheintheovenat50°Cto remove any excess water, cooled to room temperature and observedforEDXanalysis[8].
The mechanism of cellular toxicity exhibited by metal nanoparticles is through the release reactive oxygen species (ROS) (Nel etal.,2009). The antibacterial properties of silver nanoparticles are associated with slow oxidation and liberation of Ag+ ions to the environment making it an ideal biocidal agent. Silver nanoparticles are found to penetrate into the bacterial cells causing membrane damage and ultimatelythedeathoftheorganism[9].
International Research Journal of Engineering and Technology (IRJET) e ISSN:2395 0056

Volume: 09 Issue: 06 | June 2022 www.irjet.net p ISSN:2395 0072
bacteria, such as Bacillus subtilis, Staphylococcusaureus and Gram negative bacteria, Such as Pseudomonas aeruginosa, Escherichiacoli were determined by following the agar plate well diffusion method [10]. An incubated antibiotic assay by the agar well diffusion method. The agar plates were seeded with freshly prepared different pathogens. Agar wells with diameter of 6 nm were made with the help of a sterile stainless steelcoreborer.ThewellswerelabeledasA,B,C,D. The wells A and B were loaded with 80µL aqueous plant extract of Atlantiamonophylla and AgNO3: C well was loaded with 80µL contain 20µg of the gentamicin. The D well was loaded with 80µL of Ag NPs. The plates were incubated at 37ºC for 24 hours and the zone of inhibition (ZOI :mm) appearing around the wells was recorded. The microbial activity of Ag NPs was recorded by the determination of minimum inhibitory concentration (MIC). The selected four differentbacterialsuspensionswerepreparedandseededon theagarmediumrepresentedinTable1.Then0µl,20µl,40µl, 60µl,and80µlofAg NPswereloadedtotherespectivewells. All the plates were incubated at 37ºC for 24 hours, and the MICconcentrationwasrecorded[11]
Scaphiumsp. wood samples were obtained from furnishing shopkajang,Selangor.Thesamplefirstbeendrieddirectlyto sunlight and cut into a small piece Next, the small pieces of wood chips were ground into powder using grinder. Then sawdustwasdriedovernightinvacuumovenat100ºCbefore using. Then the small pieces of wood chip have been ground andpreparedfordryingprocess[12].
Sawdustextracthasbeenpreparedbytaking20gofsawdust dissolved in 150ml of distilled water boil it for 20 minutes. Afterthatfilteritthroughfilterpapertoremoveundissolved residue in which 25ml of saw dust extract were dispersed into5gofPVAina100ml beaker.Themixturewasmagnetic stirredonahotplateat50ºCintheopenatmosphere.Allthe mixture hasbeenstirred withspeed of 3anddurationin1.5 hours. A dark and viscous wood suspension with about 5wt % wood concentration were obtained. After the dissolution process,thebrownishliquidisobtained.Thentheliquidwas pouredinPetriplateforbothcontrolandtest.Incontrolonly extractof sawdust and PVA.In test extractof sawdust, PVA andbiosynthesizedAgNPswereadded[13]
10 wt.% PVA (Polyvinyl alcohol) solution was used for film formationpreparedbystirringusingmagneticstirrer(1KAC
MAGHS10digital).2.5gofPVAin25mlofdistilledwaterare used as control. 2.5g of PVA in 5ml of AgNPs and 20ml of distilled water as test. All the prepared solution is casted on the 10×10cm sheet plate and allowed to dried for 24hrs and dried AgNPs loaded PVA film is used for further characterizationandwoundhealing[14]
Antibacterial Test for Prepared Films:
20 ml of prepared agar is poured in Petri plate. After solidificationagarsurfaceisstreakedwithbacterialstrainby cotton swab. Then the prepared films are placed on the surface of agar and incubated at 37ºC for 72 hours and observedforzoneofinhibition[15]
Vero (African green monkey kidney normal cell line) was obtained from the national center for cell sciences (NCCS), Pune,India.Cellweremaintainedinthe logarithmic phaseof growth in Dulbecco’s modified eagle medium (DMEM) supplemented with 10% (v/v) heat inactivated fetal bovine serum (FBS),100µg/ml streptomycin. They were maintained at37ºcwith5%CO2in95%airhumidifiedincubator[16]
MTT (3 (4.5 dimethylthialzol 2 yl) 2,5) diphenyl terazolium bromideassayswereusedtoassessthesample'scytotoxicity against the Vero cell line (Mossman,1983). The cell was implantedinmicroplate(1 10cell/well)andincubated at37 oCfor48hoursina 5%Co2incubator,allowingittogrowto 70 80% confluence [17]. The medium was then supplemented,andthecellswereincubatedfor24hourswith different concentrations of sample (20, 40, 60, 80, and 100 g/ml). After 24 hours, the morphological changes of untreated (control) and treated cells were captured on camera under a digital inverted microscope (40x magnification). The cells were then washed with phosphate buffersaline(PBS,Ph 7.4)and20l ofMITsolution(5mg/ml) in PBS was got to add to each well. The plates were then stranded in the dark at 37oC for 2 hours. The formazan crystalsweredissolvedin100lDMSO,andtheabsorbanceat 570nm was measured spectrophotometrically. The equation wasusedtodeterminetheproportionofcellviability[18].
Cell viability (%) = (absorbance of sample /absorbanceofcontrol)×100.
International Research Journal of Engineering and Technology (IRJET) e ISSN:2395 0056

Volume: 09 Issue: 06 | June 2022 www.irjet.net p ISSN:2395 0072
This experiment was performed according to the previously reportedandstandardizedprotocol(Liangetal.,2007).Vero cell were seeded in 6 well plates (8 × 105 cells/well) and grownuntilreachedaconfluenceof90 95%,intheoptimum culture conditions [19]. In the middle of cell monolayer, a scratchwasmadebyaP10pipettetip,tomimicawound,and celldebriswereremovedbywashingwithfreshmedium.The wound was exposed with mouthwash sample (50µg/ml) for 24 48 h at 37°C in a humidified atmosphere of 5 % CO2. The negative control cells were maintained without any treatment. Scratch wound closure was analyzed in two modalities [20] Under the digital inverted microscope, by takingdigitalimagesattimezero(T0),24hours(T2),and48 hours (T3) (static imaging). Using the ImageJ processing software,thedifferencebetweenthewoundwidthsatT0and T1/T2 was used to quantify the scratch closure. The scratch closurerate(SCR)wascalculatedusingtheformuladescribed byFeliceetal.(2015):SCR=((T0 T1/T2)/T0)100,where T0 represents the scratch area at time zero and T1/T2 representsthescratchareaat24and48hours[21].
Synthesis of Ag nanoparticles by green synthesis process (from Atalantiamonophylla):
Because of the excitation of surface plasmon resonance, Ag nanoparticles in aqueous solution have a yellowish brown color.Whentheextractismixed withanaqueous solutionof Ag ion complex. The colorless to yellowish brown transition was observed [22]. It was caused by a decrease in Ag+, indicatingtheformationofAgrepresentedinFig1

Aqueous extract treated with 1mM silver nitrate changed colour from pale yellow to dark brownish. This was due to AgNPs activating surface plasmon resonance (SPR). The UV visible spectra confirm this [23]. The contrast enhancement ofthepeakintheabsorptionspectraofAgNPsat430nmafter 24 hours of incubation indicated that the particles are monodispersedrepresentedinFig2.
hr 48 hr 5th day 10th day 20th day 30th day Wavelength nm 300400500600700
Fig 2. UV-Spectroscopy peaks indicating the formation of monodispersing of AgNPs
The stability of the formed nanoparticles was also studied using UV visible spectroscopy at various time intervals (0 hours 1 month) [24]. It was discovered that as contact time is increased, the peak becomes shaper. Within 6 hours, the reaction had begun, and the SPR showed a peak at 420 nm. Following that, the peak moved from 426 nm at 12 hours to 428 nm at18hours. After 24hours,the reaction ended with an absorption peak at 430 nm mentioned in Table 2. The sharper peak indicated the formation of monodisperse nanoparticlesfrom Atalantiamonophylla extract[25]
Table 2. Represents the different peaks of AgNPs up to 14th day
International Research Journal of Engineering and Technology (IRJET) e ISSN:2395 0056 Volume: 09 Issue: 06 | June 2022 www.irjet.net p ISSN:2395 0072


The particles size, distribution, shape and morphology of silver nanoparticles (AgNPs) were characterized using Transmission electron microscopy (TEM).The TEM analysis revealedthatthesynthesizedAgNPsweremostlysphericalin shapeandwelldispersedinnaturewitha particlesize range of 30 to100nm represented in Fig 3.TEM provides the accuratesizeofthemetallicpartofthenanoparticles[26]
standard method, and ZOI was recorded among the pathogens.Anti bacterialtestsagainstgrampositivebacteria namely Bacillus subtilis, Staphyloccocusaureus and gram negative bacteria namely Escherchia coli and Pseudomonas aeruginosaall. In the well plates, sample was injected plates werekeptat37ºCforincubation24hrs.[28].Thenthezone of inhibition is measured for four pathogens is shown in Table3andFig5.

The reduced silver nanoparticles were subjected to EDX analysis with an optical adsorption characteristic peak at 3KeVrepresentedinFig4[27]




Biosynthesized AgNPs were studied for their antibacterial activity against different pathogenic bacteria by following

International Research Journal of Engineering and Technology (IRJET) e ISSN:2395 0056 Volume: 09 Issue: 06 | June 2022 www.irjet.net p ISSN:2395 0072

Development,CharacterizationandMolecularstimulation studies of Metoclopramid HCl and Tramadol HCl Bilayer Tablet. Research Journal of Pharmacy and Technology Vol.15No.2:p.529 4.10.52711/0974 360X.2022.00085
3. M. Habeeb, A. Sugumaran, (2022) Strategies of Cell Signaling and Critical Focus on Etiology of Hepatocellular Carcinoma, Vol.12, pp.5187 5198. https://doi.org/10.33263/BRIAC124.51875198
4. Babu, P.R., Sastry, T.P., Rose, C. and Rao, N.M. (1997) ‘Hydrogels based on gelatin poly (hydroxyethyl methacrylate) and poly (butylacrylate) graft copolymer impregnated with fibrin’, Journal of Applied Polymer Science,Vol.65,No.3,pp.555 560.
In the present investigation, The AgNPs was prepared by green synthesis process from AgNO3 solution through the extract from the leaves of plant Atlanta monophyla and impregnatedthesilvernanoparticleswithcellulosefibersfor wound healing activity. From the UV Spectroscopy, the formationofstablenanoparticleswasconfirmedbetweenthe 300nm to 700 nm. It was found that Atlantamonophylawas stable showing the absorbance of 430nm. The size of AgNPS anddifferentelementsinsamplecompositionwasconfirmed by TEM and EDX respectively. Antibacterial activity of synthesizedsilvernanoparticlesandimpregnatedAgNPswas carried out in liquid growth medium against four pathogens conducted and it was found to be more antibacterial effect whencomparetocontrol.Thebiocompositeswereprepared by using conventional techniques and its invitro cytotoxicity wasevaluatedbyMTTin3T3fibroblastcelllinewasfoundto be99.20%viabilitywitha concentrationof20µl/ml.Finally, weconclude the RC F Agbiocomposite prepared from plant Atalantia monophylla was consider may be a potential candidate as a wound dressing material for treating the wound.
1.Ahamed,M.I.N.andSastry,T.P.(2011)‘Aninvivostudy on the wound healing activity of cellulose chitosan compositeincorporatedwithsilvernanoparticles’,Int.J.of Research in Ayurveda and Pharmacy, Vol. 2, No. 4, pp.1203 1209.
2. Mohammad Habeeb, K.L. Deepthi, M. Vijaya Vara s Prasad, N.Irfan, Shaik Liakhat Ali, K. Navyaja. (2022)
5.HabeebMD etal. (2012)FormulationandEvaluationof Tramadol Hcl bilayer tablets, International Journal of Bio assays Vol. 02 No. 01, pp.319 324.
6. Salama, A.; Abou Zeid, R.E.; Cruz Maya, I.; Guarino, V. Soyproteinhydrolysategrafted cellulose nanofibrilswith bioactive signals for bone repair and regeneration. Carbohydr.Polym.2019,229,115472.
7. Burdus, el, A. C.; Gherasim, O.; Grumezescu, A.M.; Mogoantă, L.; Ficai, A.; Andronescu, E. Biomedical Applications of Silver Nanoparticles: An Up to Date Overview.Nanomaterials2018,8,681.
8. Fu, F.; Gu, J.; Cao, J.; Shen, R.; Liu, H.; Zhang, Y.; Liu, X.; Zhous, J. Reduction of Silver Ions Using an Alkaline Cellulose Dope: Straightforward Access to Ag/ZnO Decorated Cellulose Nanocomposite Film with Enhanced Antibacterial Activities. ACS Sustain. Chem. Eng. 2018, 6, 738 748.
9. Huang, Y.; Zhu, C.; Yang, J.; Nie, Y.; Chen, C.; Sun, D. Recentadvancesinbacterialcellulose.Cellulose2013,21, 1 30.
10. Zhu, C.; Li, F.; Zhou, X.; Lin, L.; Zhang, T. Kombucha synthesized bacterial cellulose: Preparation, characterization, and biocompatibility evaluation. J. Biomed.Mater.Res.PartA2014,102,1548 1557.
11. Zeng, M.; Laromaine, A.; Roig, A. Bacterial cellulose films:Influenceofbacterialstrainanddryingrouteonfilm properties.Cellulose2014,21,4455 4469.
12. Kuci ´nska Lipka, J.; Gubanska, I.; Janik, H. Bacterial cellulose in the field of wound healing and regenerative
medicine of skin: Recent trends and future prospectives. Polym.Bull.2015,72,2399 2419.
13. Branco da Cunha, C.; Klumpers, D.D.; Li, W.A.; Koshy, S.T.; Weaver, J.C.; Chaudhuri, O.; Mooney, D.J. Influence of the stiffness of three dimensional alginate/collagen I interpenetrating networks on fibroblast biology. Biomaterials2014,35,8927 8936.
14.Ifuku,S.;Tsuji,M.;Morimoto,M.;Saimoto,H.Synthesis of Silver Nanoparticles Templated by TEMPO Mediated Oxidized Bacterial Cellulose Nanofibers. Biomacromolecules2009,10,2714 2717.
15. Li, X.; Chen, S.; Hu, W.; Shi, S.; Shen, W.; Zhang, X.; Wang, H. In situ synthesis of CdS nanoparticles on bacterial cellulose nanofibers. Carbohydr. Polym. 2009, 76,509 512.
16. Wen, X.; Zheng, Y.; Wu, J.; Yue, L.; Wang, C.; Luan, J.; Wu, Z.; Wang, K. In vitro and in vivo investigation of bacterial cellulose dressing containing uniform silver sulfadiazine nanoparticles for burn wound healing. Prog. Nat.Sci.Mater.Int.2015,25,197 203.
17. Khamrai, M.; Banerjee, S.L.; Paul, S.; Ghosh, A.K.; Sarkar, P.; Kundu, P.P. A Mussel Mimetic, Bioadhesive, Antimicrobial Patch Based on Dopamine Modified Bacterial Cellulose/rGO/Ag NPs: A Green Approach toward Wound Healing Applications. ACS Sustain. Chem. Eng.2019,7,12083 12097.
18. Alonso Díaz, A.; Floriach Clark, J.; Fuentes, J.; Capellades, M.; Coll, N.S.; Laromaine, A. Enhancing LocalizedPesticideActionthroughPlantFoliagebySilver CelluloseHybrid Patches.ACSBiomater.Sci.Eng.2019,5, 413 419.
19.Wasim,M.;Mushtaq,M.;Khan,S.U.;Farooq,A.;Naeem, M.A.; Khan, M.R.; Salam, A.; Wei, Q. Development of bacterial cellulose nanocomposites: An overview of the synthesis of bacterial cellulose nanocomposites with metallic and metallic oxide nanoparticles by different methods and techniques for biomedical applications. J. Ind.Text.2020.
20. Zhang, S.; Tang, Y.; Vlahovic, B. A Review on Preparation and Applications of Silver Containing Nanofibers. Nanoscale Res. Lett. 2016, 11, 80 87. [CrossRef] 61. Ferraria, A.M.; Boufi, S.; Battaglini, N.; Do Rego, A.M.B.; Reivilar, M. Hybrid systems of silver nanoparticles generated on cellulose surfaces. Langmuir 2010,26,1996 2001.
International Research Journal of Engineering and Technology (IRJET) e ISSN:2395 0056 Volume: 09 Issue: 06 | June 2022 www.irjet.net p ISSN:2395 0072 © 2022, IRJET | Impact Factor value: 7.529 | ISO 9001:2008 Certified Journal | Page678

21. Lee, H.Y.; Park, H.K.; Lee, Y.M.; Kim, K.; Park, S.B. A practicalprocedureforproducingsilvernanocoatedfabric and its antibacterial evaluation for biomedical applications.Chem.Commun.2007,2959 2961.
22. Lee, H.Y.; Park, H.K.; Lee, Y.M.; Kim, K.; Park, S.B. A practicalprocedureforproducingsilvernanocoatedfabric and its antibacterial evaluation for biomedical applications.Chem.Commun.2007,2959 2961.
23. Mekkawy, A., Fathy, M., and El Shanawany, S. (2013). Formulationandinvitro evaluationoffluconazoletopical gels. Br. J. Pharm. Res. 3, 293 313. Mohamad, N., Mohd Amin,M.C.,
24. Pandey, M., Ahmad, N., and Rajab, N. F. (2014). Bacterial cellulose/acrylic acid hydrogel synthesized via electron beam irradiation: accelerated burn wound healing in an animal model. Carbohydr. Polym. 114, 312 320.doi:10.1016/j.carbpol.2014.08.025
25.Morones,J.R.,Elechiguerra,J.L.,Camacho,A.,Holt,K., Kouri, J. B., Ramírez, J. T., et al. (2005). The bactericidal effect of silver nanoparticles. Nanotechnology. 16, 2346 2353.doi:10.1088/0957 4484/16/10/059
26. Noruzi, M. (2015). Biosynthesis of gold nanoparticles using plant extracts. Bioprocess Biosyst. Eng. 38, 1 14. doi:10.1007/s00449 014 1251 0
27. Ong, C., Yung, L. Y., Cai, Y., Bay, B. H., and Baeg, G. H. (2015). Drosophila melanogaster as a model organism to study nanotoxicity. Nanotoxicology. 9, 396 403. doi: 10.3109/17435390.2014.940405
28. Rai, M., Kon, K., Ingle, A., Duran, N., Galdiero, S., and Galdiero, M. (2014). Broadspectrum bioactivities of silver nanoparticles: the emerging trends and future prospects. Appl. Microbiol.Biotechnol. 98, 1951 1961. doi: 10.1007/s00253 013 5473 x
29.Huang,H.,Qi,X.,Chen,Y.,and Wu,Z.(2019).Thermo sensitive hydrogels for delivering biotherapeutic molecules: A review. Saudi Pharma. J. 27, 990 999. doi: 10.1016/j.jsps.2019.08.001